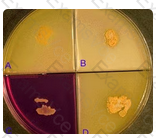

ASCP ASCP-MLT Question Answer
One of the key characteristics to the identification of Nocardia asteroides is its inability to hydrolyze casein, tyrosine or xanthine, as shown in this photograph. Nitrates are reduced to nitrites. Both Nocardia brasiliensis and Actinomadura madurae hydrolyze both casein and tyrosine; Streptomyces griseus hydrolyzes all three of the substrates.
Illustrated in this photograph is an agar quadrant plate containing casein (A), tyrosine (B), nitrate (C) and xanthine (D). None of the substrates have been hydrolyzed and nitrate has been reduced. The most likely identification is:
ASCP ASCP-MLT Summary
- Vendor: ASCP
- Product: ASCP-MLT
- Update on: Apr 7, 2026
- Questions: 572

